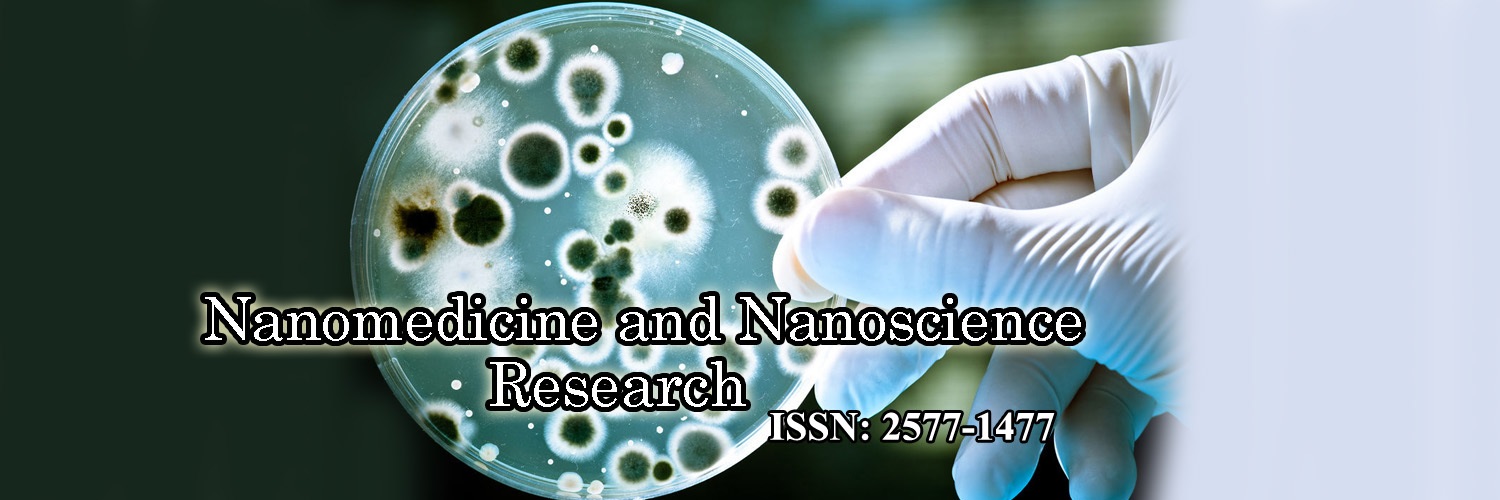
New Generation of Photosensitizers: The Conjugate of Folic Acid with Nanoparticles and Chlorine E6
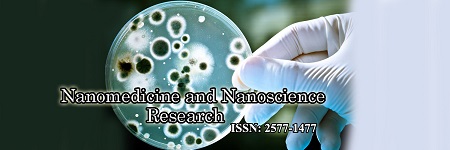
Structural and Electrical Behaviours of ZnO Nanoparticle-V2O5-Mn2O3 Varistor before and after Thermal Annealing in Different Atmospheres

Precision Medicine: Carbon Nanotubes as Potential Treatment for Human Brain Disorders-Based Mitochondrial Dysfunctions with a First Principles DFT-Study
Patrícia Viera de Oliveira, Michael González-Durruthy*, José M. González-Durruthy, Solange Binotto Fagan*
Nanomedicine and Nanoscience Research
Different Aspects of Chemical and Biochemical Methods for Chitin Production a Short Review
Broquá J, Zanin B.G, Flach A.M, Mallmann C, Taborda F.G.D, Machado L.E.L, Alves S.M.L, Silva M.M, Dias R.J.S.P, Reis O. V, Pighinelli L*
Nanomedicine and Nanoscience Research
To Basic Trends of Analytic Electrochemistry in Biology and Nanomedicine
Raoul R. Nigmatullin*, Herman C. Budnikov
Nanomedicine and Nanoscience Research
Molecular Junction based on ZigZag Silicene Planar NanoRibbon (ZZSiPNR): Density Functional Theory (DFT) and Extended Huckel Theory / Non-Equilibrium Green Function (EHT/NEGF)
Rafaela Farinha Felipe, Kazuko Ramos Nisioka, Jordan Del Nero*, Vicente Ferrer Pureza Aleixo, Carlos Alberto Brito da Silva Jr
Nanomedicine and Nanoscience Research
Development of a Novel Tyrosinase Amperometric Biosensor Based on Tin Nanoparticles for the Detection of Bisphenol A (4.4-Isopropylidenediphenol) in Water
Noluthando Mayedwa*, Aline Simo, Itani Given Madiba, Lisebo Phelane, Rachel Fanelwa Ajayi, Nolubabalo Matinise, Nametso Mongwaketsi, Malik Maaza
Nanomedicine and Nanoscience Research
Effects of Anti-Solvent Flow Rate in the Microfluidic Preparation of Nanoparticle for Biomedicine Application
Mahdi Aghajani*, Elham Barkhordari, Seyed Hossein Mostafavi
Nanomedicine and Nanoscience Research
New Generation of Photosensitizers: The Conjugate of Folic Acid with Nanoparticles and Chlorine E6
V. Lapina*, T. Pavich, S. Bushuk, J. Kalvinkovskaya, A. Vorobey, B. Bushuk
Nanomedicine and Nanoscience Research
Optimizing Nanoparticle Design for Gene Therapy: Protection of Oligonucleotides from Degradation Without Impeding Release of Cargo
Oksana Fihurka, Juan Sanchez-Ramos*, Vasyl Sava
Nanomedicine and Nanoscience Research
Doxorubicin Stimulates the Activity of the Na/I Symporter in Breast Cancer Cells
Neena Xavier, Alex Harrelson, Linh Khanh Pham, Nghi Dang, Remo George, Norman Bolus, Joe Garner, Kathy Nugent, M. Tino Unlap*, Dina Avery
Nanomedicine and Nanoscience Research
Two Glycoconjugates of Dopamine, IPX-750 and IPX-760, Attenuate α-Synuclein Oligomerization
Alex Harrelson, Neena Xavier, Khushbu Viralkumar Patel, Yi En Huang, Joe Garner, Kathy Nugent, M. Tino Unlap*, Zainab Suleiman, Tawnya Yates, Dina Avery
Nanomedicine and Nanoscience Research
Is a Cumulative Exposure to a Background Aerosol of Nanoparticles Part of the Causal Mechanism of Aerotoxic Syndrome?
C. Vyvyan Howard1*, David W. Johnson2, John Morton3, Susan Michaelis4, David Supplee5, Jonathan Burdon6
Nanomedicine and Nanoscience Research
Characterization, Optical Properties and Electron (Exciton)-Phonon Interaction in Bulk In2Se3 Crystals and InSe Nanocrystals in In2Se3 Confinement
Yuriy I. Zhirko1*, Vasiliy M. Grekhov1, Zakhar D. Kovalyuk2
Nanomedicine and Nanoscience Research
Nanorobotic Manipulation of Thin-film Graphite Sheet for 3D Cubic Structures
Takafumi Fujiwara1*, Masahiro Nakajima2, Yasuhisa Hasegawa2, Toshio Fukuda1,3, Huang Qiang,3
Nanomedicine and Nanoscience Research
Biomaterials for Ocular Implants Following Radical Surgical Interventions
Catalu Corina Teodora1, SanzianaLuminitaIstrate1*, Liliana MaryVoinea1, MohammadAl Hammoud1, Madalina Laura Popescu2, Radu Ciuluvica3
Nanomedicine and Nanoscience Research
Metallodendrimers as a Catalyst: An Overview
Shivani R.Pandya1*, Rajlakshmi Chetty2, Sachin B Undre3
Nanomedicine and Nanoscience Research
A Review on Nano-Silica Based Concrete
Bashar S Mohammed*, Veerendrakumar C Khed, Muhd Fadhil Nuruddin
Nanomedicine and Nanoscience Research
Steam Reforming of Toluene on Ni/Phyllosilicate: Enhanced Catalytic Activity and Stability
Chun Shen*, Hao Yu, Wuqing Zhou, Shina Ma, Tianwei Tan
Nanomedicine and Nanoscience Research
Making and Evaluation of Nanopore Hydroxysodalite Zeolite Membranes for Pervaporation Applications
Mansoor Kazemimoghadam1*, Toraj Mohammadi2
Nanomedicine and Nanoscience Research
Innovative Approach to Sustain the Release of the Drug from Conventional Dosage Form Nifedipine Sustained Release Tablet
Prashant Khemariya1*, Kaushal Dubey2, Richa Khemariya3
Nanomedicine and Nanoscience Research
SOA Based All-Optical N-Bit-Binary Data Multiplier Design
Suresh Ponnan1*, Saravanakumar Umathurai1, Revathi Munirathinam2
Nanomedicine and Nanoscience Research
Affinity of Bacterial Produced Poly (γ-Hydroxybutyrate) Nanoparticles to GHB Sites in Rat Brain
Mohsin Shah1,2*, Sung Chul Yoon1*, Mun Hwan Choi1, Haroon Badshah3, Myeong Ok Kim3
Nanomedicine and Nanoscience Research
Land Cover Pollution from Mining and Metallurgical Enterprises and Biotechnological Method of Remediation Using Biochar
Seitkhan Azat1,2*, Zulkhair A Mansurov1,2, Farida E Kozybaeva3, Gulzhan B Beiseyeva3, Ashat Murataliyev3
Nanomedicine and Nanoscience Research